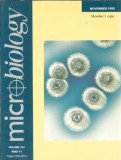
Micriobiology - 1995, Editura Society for General Microbiology, 300 Pagini, Stare Buna

Micriobiology - june 1995
-
Ramburs prin Garantia de Livrare

Curierul special îți livrează produsul pe care tu îl achiți la primire. Dacă produsul nu este ca în descriere, îți recuperezi banii, inclusiv taxele de transport.
- Online


Descriere
Raporteaza produsVânzatorul este direct răspunzator pentru produsul afișat în această pagină.
Specificatii
Editura: Society for general microbiology
An: 1995
Pagini: 300
Ne pasă de experiența ta de lectură! De aceea, garantăm că toate
volumele sunt în stare bună, gata să își găsească locul în
biblioteca ta.
Beneficiezi de profesionalism deplin: oferim factură fiscală și ne
asigurăm că pachetul tău este ambalat corespunzător împotriva
șocurilor. Dacă ai întrebări suplimentare despre această ediție, nu
ezita să ne contactezi prin mesageria Okazii!
Tags: literatura clasica, romane celebre, literatura romana,
literatura straina, autori clasici, proza, poezie, teatru,
dramaturgie, eseistica, memorii, jurnale, biografii, autobiografii,
filosofie, psihologie, spiritualitate, religie, istorie, critica
literara, studii, dictionare, enciclopedii, editie de colectie,
editie veche, editie princeps, carti rare, carti de colectie,
bibliofilie, coperta cartonata, coperta brosata, editie ilustrata,
format buzunar, Biblioteca pentru Toti, BPT, Editura Univers,
Editura Humanitas, Editura Polirom, Editura Litera, Editura
Minerva, idei de cadou, cadou pentru cititori, carti pentru elevi,
bibliografie scolara, lectura obligatorie, carti pentru studenti,
carti de vacanta, lectura de seara, dezvoltare personala, educatie,
cultura generala.
Galerie foto

Modalitati de livrare si plata
LIVRARE
In Sabaoani
-
- Prin curier cu Garantia de Livrare - 19.1 Lei in max. 2 zile lucratoare

In Romania:
-
- Prin curier cu Garantia de Livrare - 19.1 Lei in max. 2 zile lucratoare

- Ridicare de la locker Miercuri, 29 Apr. - 13,09 Lei
PLATA
- - Ramburs prin Garantia de Livrare

Curierul special îți livrează produsul pe care tu îl achiți la primire. Dacă produsul nu este ca în descriere, îți recuperezi banii, inclusiv taxele de transport.
- - Online
Politica de retur
- - Produsul se poate returna in maxim 3 zile lucratoare
- - Metoda de retur: Ramburs contravaloare produs
- - Costul transportului va fi suportat de catre cumparator
- - Alte detalii: Retur acceptat in conditiile Garantiei de Livrare
Spune-ti parerea acordand o nota produsului